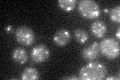
YKL063C
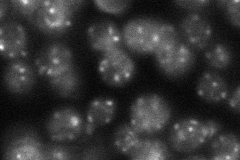
YKL063C
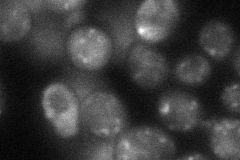
YKL063C

View description
Putative protein of unknown function; green fluorescent protein (GFP)-fusion protein localizes to the Golgi
Localization:
Intensity:
Fold change:
Significance:
-
C’ GFP library in SD
punctate26.43 -
N' NOP1pr-GFP in SD

punctate109.311 -
N' TEF2pr-mCherry in SD

vacuole177.424 -
N' NATIVEpr-GFP in SD
punctate38.5552 -
N' TEF2pr-VC and Cyto-VN in SD
punctate40.6988 -
C’ GFP library in SD+DTT

punctate17.440.65Yes -
C’ GFP library in SD+H2O2

punctate23.950.9No -
C’ GFP library in Starvation Media

punctate21.720.82No -
C’ GFP library on the background of Pup2-DaMP

punctate -
C’ GFP library on the background of CCT mutant

punctate23.18310.877025No
